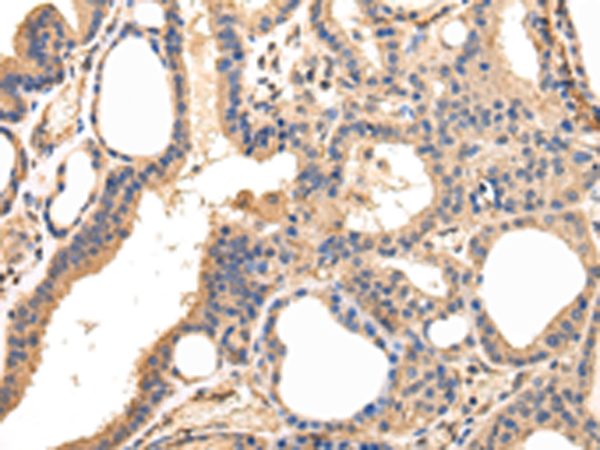

-
分类: 科研抗体货号: P08958别名: ISOT应用: IHC反应种属: Human, Mouse
-
分类: 科研抗体货号: P08959别名: UNPH4; UNPH-2应用: IHC反应种属: Human, Mouse, Rat
-
分类: 科研抗体货号: P08978别名: HCCS1; PCH2E; hVps53L; pp13624应用: WB,IHC反应种属: Human, Mouse
-
分类: 科研抗体货号: P08957别名: PIR1应用: IHC反应种属: Human
-
分类: 科研抗体货号: P08977别名: DERP9; EAP20; FAP20应用: WB反应种属: Human, Mouse, Rat
-
分类: 科研抗体货号: P08987别名: WBSCR24应用: IHC反应种属: Human, Mouse
-
分类: 科研抗体货号: P08975别名: NEDF; VPS24; CGI-149应用: WB,IHC反应种属: Human, Mouse, Rat
-
分类: 科研抗体货号: P08986别名: HCRP1; PQBP2; SPG53应用: WB,IHC反应种属: Human, Mouse
-
分类: 科研抗体货号: P08974别名: hVPS16应用: IHC反应种属: Human, Mouse
-
分类: 科研抗体货号: P08985别名:应用: IHC反应种属: Human, Mouse, Rat

鄂公网安备42018502007531号
鄂公网安备42018502007531号

